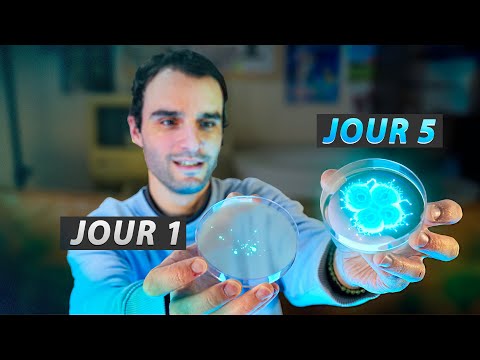

- Sortie originale
- Épisode précédent S11E64 - L’expérience pour voir le son ! (C’est fou)
- Numéro S11E65
- Pays États-Unis
-
Liens externes
Fiche YouTube
-
Dernière mise à jour
27 mai 2026 - 09:41
sur 11 bases de données
On développe des bactéries lumineuses !
Essayons d'élever des bactéries bioluminescentes, ça ne va pas être simple, mais on peut y arriver ! Je veux un max de lumière !
Montage FX : https://www.youtube.com/c/jimwild3
Illustration : https://bit.ly/2o1bwwM
Ecriture : https://www.youtube.com/c/LesRecapsduMonde

Prochain épisode
S11E66 - Les coffres sont-ils vraiment incraquables ? (On fait le test !)
Voir l'épisode